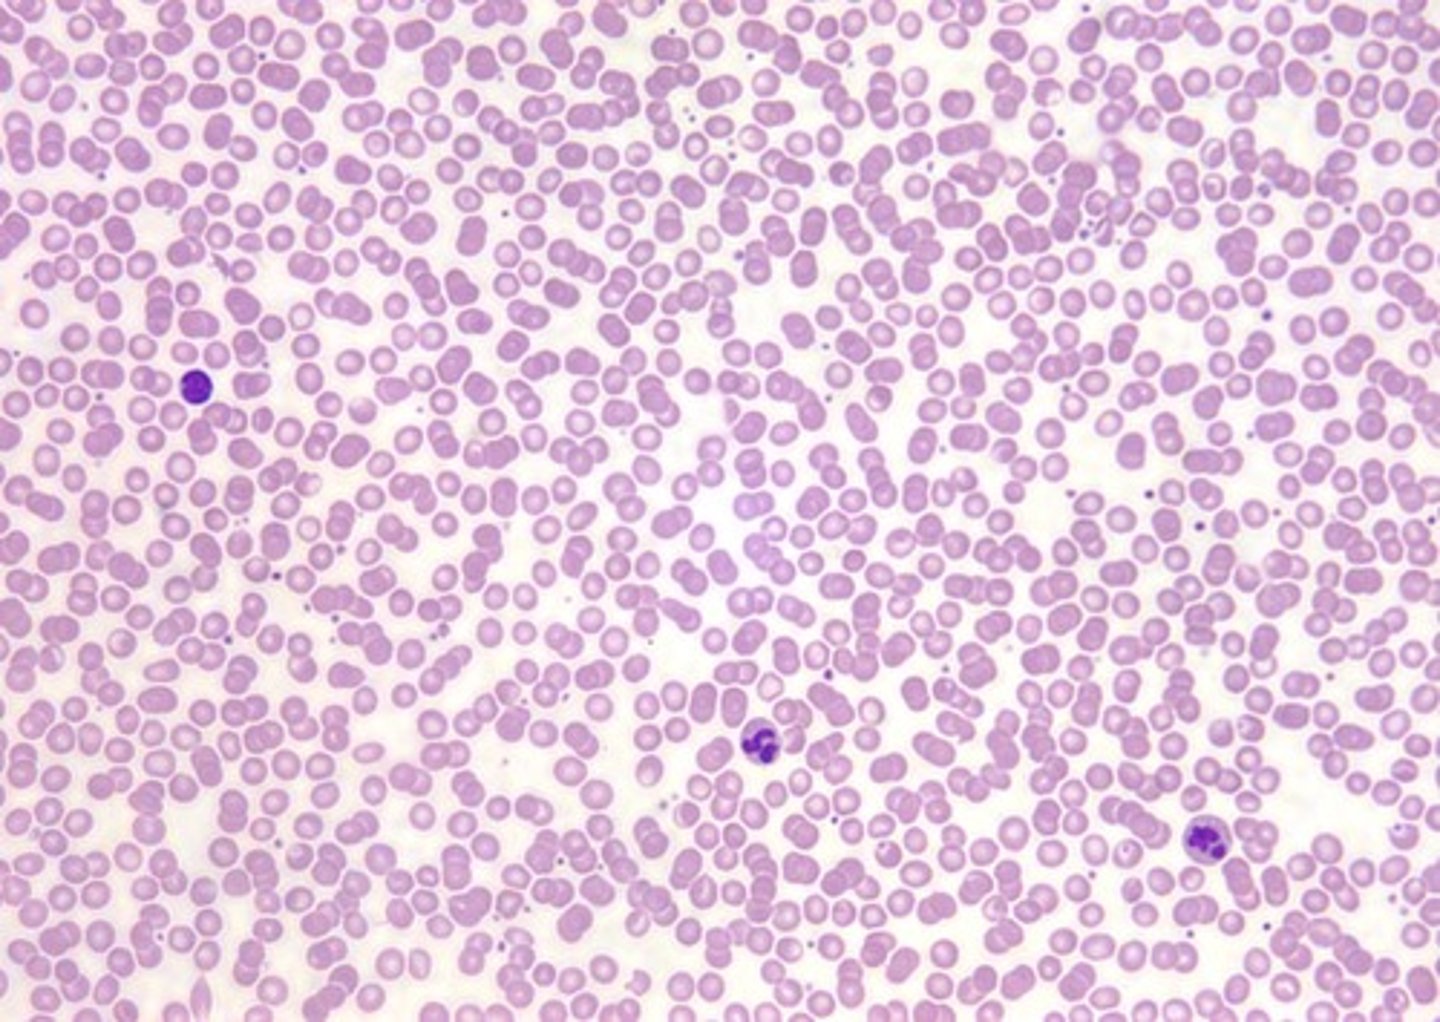

BIO-50A Exam 2 Flashcards: Key Biology Terms & Functions
1/38
There's no tags or description
Looks like no tags are added yet.
Name | Mastery | Learn | Test | Matching | Spaced |
|---|
No study sessions yet.
39 Terms
simple squamous ET
location: kidneys
function: filtration & absorption
special structures: flat nuclei
What tissue is this?

simple squamous ET
location: lungs
function: filtration & absorption
special structures: flat nuclei
What tissue is this?

simple cuboidal ET
location: kidneys
function: secretion & absorption
special structures: round, in center nuclei
What tissue is this?

simple columnar epithelium
location: digestive tract
function: secretion & absorption
special structures: goblet microvilli
What tissue is this?

pseudostratified ciliated columnar ET
location: intestines
function: secrete mucous
special structures: goblet cilia
What tissue is this?

nonkeratinized stratified squamous ET
location: mouth
function: protection
special structures: live apical nuclei
What tissue is this?

keratinizing stratified squamous ET
location: skin (epidermis)
function: protection
special structures: dead apical nuclei
What tissue is this?

transitional ET
location: bladder
function: expand & contract
special structures: round nuclei when relaxed, flat nuclei when active
What tissue is this?

areolar loose CT
location: under epithelia
function: universal packing material
special structures: fibroblasts and mast cells
What tissue is this?

adipose loose CT
location: hypodermis
function: fat storage
special structures: large fat deposit
What tissue is this?

reticular loose CT
location: lymph nodes
function: support organs
special structures: reticular tissue & red blood cells
What tissue is this?

dense regular CT
location: tendons & ligaments
function: resist pulling in 1 direction
special structures: flat nuclei
What tissue is this?

dense irregular CT
location: dermis
function: resist pulling in multiple directions
special structures: swirly tissue
What tissue is this?

elastic dense CT
location: large arteries
function: stretch & recoil
special structures: elastic fibers & collagen
What tissue is this?

hyaline cartilage
location: nose, trachea
function: structure, support
special structures: no visible fibers, chondroblasts and chondrocytes
What cartilage is this?

elastic cartilage
location: ears, epiglottis
function: structure
special structures: visible elastic fibers
What cartilage is this?

fibrocartilage
location: intervertebral discs
function: bares weight
special structures: *visible collagen fibers
What cartilage is this?

osseous CT
location: skeleton
function: structure & protection
special structures: osteon
What tissue is this?

blood CT
location: blood vessels
function: transport nutrients, wastes, & other substances
special structures: plasma, red and white blood cells
What tissue is this?
skeletal muscle
location: attached to bones
function: voluntary movement & control
special structures: myofilaments; cylindrical and striated
What muscle is this?

cardiac muscle
location: walls of the heart
function: involuntary blood circulation
special structures: myofilaments; branching and striated
What muscle is this?

smooth muscle
location: stomach
function: involuntary, propels substances
special structures: myofilaments; no striations
What muscle is this?

nervous tissue
location: brain & spinal cord
function: regulat & control body functions
special structures: neurons & supporting cells
What tissue is this?

cutaneous membranes
location: skin
function: protection
special structures: epidermis (ET) over dermis (CT); dry
What membrane is this?

mucous membranes
location: nasal cavity
function: protection
special structures: ET over lamina propria (CT); moist
What membrane is this?

serous membranes
location: pericardium
function: protection
special structures: mesothelium (ET) over CT; moist
What membrane is this?

epidermis
location: superficial region of skin
function: protection
special structures: avascular ET; keratinocytes & melanocytes
What layer of skin is this?

dermis
location: underlies epidermis
function: thermoregulation, sense touch
special structures: vascular CT
What layer of skin is this?

NOT SKIN; hypodermis
location: deep to skin
function: protection
special structures: the subcutaneous layer; mostly adipose tissue
What layer of skin is this?

stratum basale
location: base layer
function: attach to dermis
special structures: single row of cells
What layer of skin is this?

stratum spinosum
location: 2nd layer
function: resist tension
special structures: several prickly layers
What layer of skin is this?

stratum granulosum
location: 3rd layer
function: resist water
special structures: start of keratinization
What layer of skin is this?

stratum lucidum
location: 4th layer only in thick skin
function: protection
special structures: thin, translucent
What layer of skin is this?

stratum corneum
location: apical layer
function: protection
special structures: dead keratinized cells
What layer of skin is this?

hair papilla
location: dermis
function: nutrient supply
special structures: blood vessels
What is being depicted here?

eccrine sweat glands
location: everywhere
function: thermoregulation
special structures: water salt secretions
What kind of gland is this?

apocrine sweat glands
location: anogenital area; near hair follicle
function: possibly sexual
special structures: fatty protein secretions
What kind of gland is this?

Pacinian's corpuscle
location: hypodermis
function: deep pressure
special structures: surrounded by adipose
Which corpuscle is this?

Meissner's corpuscle
location: dermal papilla
function: fine, detailed touch
special structures:
Which corpuscle is this?
